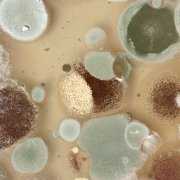

Mold’s Favorite Places in Your Home
Fungi (mold) grow by releasing reproductive cells (spores) into the air, just as plants reproduce by spreading seeds. The airborne spores are invisible to the naked eye, which is a major reason mold is such a problem. It is not uncommon to find hundreds or even thousands of mold spores per cubic foot of indoor […]


 Mold-Help.org
Mold-Help.org ©Lyudmila Suvorova/Shutterstock
©Lyudmila Suvorova/Shutterstock Humanillnesses.com
Humanillnesses.com




